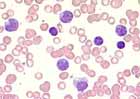

Kurzbeschreibung:
Bei einer akuten (primären) HIV-Infektion beobachtet man 2 bis 12 Wochen nach der Ansteckung häufig ein Mononukleose- oder grippeähnliches Krankheitsbild. Zu diesem Zeitpunkt bilden sich auch Antikörper gegen HIV (Serokonversion). Nicht ganz 50% der primären HIV-Infektion verlaufen asymptomatisch. Zwischen Ansteckung und Serokonversion liegt das so genannte serologische Fenster, d.h. der Patient hat noch keine Antikörper gegen das HI-Virus gebildet, kann aber das Virus weitergeben. Um die primäre HIV-Infektion zu diagnostizieren, genügt es deshalb nicht, nur die Antikörper gegen HIV zu suchen. Die Diagnose wird durch Nachweis des HIV-p24-Antigens im Serum und der HIV-RNA im Plasma mittels reverser Transkriptase-Polymerase-Kettenreaktion (RT-PCR) gestellt.
Klinisches Bild:
Das klinische Bild einer akuten HIV-Infektion ist dem der Mononukleose sehr ähnlich, mit Fieber, Lymphadenopathie, Pharyngitis, Hautausschlag, Muskel- und Gelenksschmerzen sowie Kopfschmerzen. Die Möglichkeit eines akuten HIV-Infektes muss darum bei solchen Patienten immer in Betracht gezogen werden, insbesondere wenn ein Risikoverhalten vorliegt.
Hämatologie:
Das Blutbild ähnelt sehr stark dem einer Mononukleose.